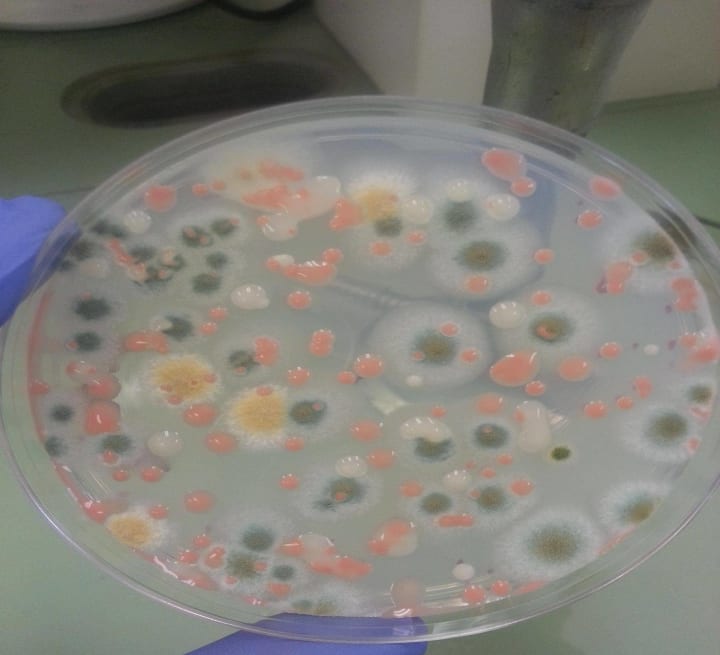

The International Space Station is full of bacteria! Astronauts are troubled by this, why can't they remove it?
There's nothing more comforting than taking a shower after a big cleaning... wait, now we're in space, what if we want to have a cleaning?

Space Station Cleanup
Open the windows, let the sun shine, clean the table with a rag, then take a mop and carefully clean the floor, and if you can, it's best to take a shower.
There is nothing more comforting than taking a shower after cleaning, wait a minute, now we are in space, want to clean how to do?
In fact, this problem also plagued the astronauts in the International Space Station, after all, the space environment can not be like the Earth in general, just open the windows to ventilate the thing is quite deadly.
Ultraviolet light to kill the poison? If the interior of the space station can receive ultraviolet cleaning, I am afraid that within a few years will have to completely replace an astronaut.
Bacteria are always everywhere, even the International Space Station is full of them.
Trying to avoid this completely is impossible, and although astronauts cleaned carefully at the time of rocket launch, it is impossible for humans to completely remove the bacteria attached to our bodies.
Today in the International Space Station, scientists have found staphylococci, bacilli - Bacillus-like bacteria, fungi, molds and more.
These are all very common bacteria and strains of bacteria on Earth, and most of them will be found in your own refrigerator. If there are these things in the refrigerator, a disinfectant wipe can completely solve the problem.
Various bacteria in the International Space Station
However in microgravity, cleaning these bacteria may not be as easy as we think.
If you simply wipe, then it may cause a mixture of different chemicals and bacteria, which of course on Earth we can clean in the sink.
But in the International Space Station must take into account the existence of pollution problems, and water is a very important resource here, can not be used casually to do hygiene.
Some people may say, it is not simple? Directly with the pharmaceutical ingredients of disinfectants to remove the matter is not done?
Space selfies are easier than cleaning
Nice idea, but it wouldn't work. If we just use one cleaning agent for bacteria elimination, then these bacteria will easily develop resistance.
Then, the space station will always exist in these bacteria can not be killed. As astronauts certainly do not want to open a drawer full of various disinfectants.
And disinfectants no matter how to use, whether it is sprayed or liquid flow or, eventually in the space station microgravity environment must find something to collect it.
Originally intended to clean up the garbage, the result of the garbage more and more, the cleaning becomes meaningless.
Space life can not avoid these garbage

The pesky bacteria problem
On the International Space Station, there are usually six astronauts working up there, which is obviously full of variables and unknowns.
In addition, when there are more people, there are more bacteria.
Early NASA in the study of the impact of space life on the human body, from a number of aspects of the analysis of daily living life will be caused to the astronauts what trouble.

The circulation system and life support system in the International Space Station has a number of filters, which can add some substances with antibacterial effect.
For example, in the water purifier, the concentration of silver ions can be adjusted to eliminate some harmful microorganisms or bacteria.
In addition, the air purifier can also be heated to achieve the effect of bacterial inactivation by way of warming.
But what needs to be understood is that these are only preventive measures, and the ISS has been in use for more than 20 years, so obviously those bacteria will certainly grow over time.
In terms of the Russian Mir module of the International Space Station, since its operation in 1998, there have been many power outages, computer system failures, aging wiring and so on.
These situations alone give bacteria the opportunity to take advantage of, even if the prevention work is in place, it is difficult to avoid the sudden unexpected situation.
Astronauts have found in the past that some water balloons are filled with a variety of bacteria, fungi and mites during inspections of the space station.
The Russian Mir module

And these creatures will also have an impact on the space station's rubber seals, bacteria, mites, these creatures will be acid, and the acid will slowly eat up the rubber seals.
When the time comes, it may really come to "open the window", such problems for the astronauts troubled.
Over the past few years, astronauts have been subjected to increasingly high levels of stress caused by these microorganisms, and because of their ability to adapt to perform well in space, eventually these substances will certainly cause contamination.
The hygiene of the space environment is a matter of safety

Although scientists have not found bacteria with increased drug resistance in past scientific studies, researchers are not sure if this will change in the future.
For bacteria, their ability to resist foreign invasion relies on their own biofilms or multibacterial assemblies.
Biofilms can attack metals as well as plastics, and bacterial aggregates can grow on different surfaces.
Bacterial biofilm behavior

Scientists found in further research, growing on the walls of the International Space Station mold is vulnerable to high levels of radiation exposure.
And these molds tend to survive, thus gaining greater resistance.
Space mold growth capacity is stronger

To clean these bacteria, it is best to start with the surfaces where the bacteria live so that the environment they are in can be self-cleaning.
For example, compounds are applied to areas that tend to harbor bacteria. Titanium dioxide is often used as a surface cleaner and is the same compound used in hospitals to clean glass and form antibacterial surfaces on Earth.
There are also photosensitive coatings, which change when the material is exposed to specific wavelengths.
The main principle is photocatalytic oxidation, when they are exposed to ultraviolet light, titanium dioxide breaks down the water vapor in the air, thus oxidizing microorganisms. This effectively dissolves the bacterial film with which it comes into contact.
Titanium dioxide disinfection coating treatment

Another advantage of using this photosensitive material is that the photocatalytic oxidation does not cause resistance to these microorganisms, making it a relatively safe cleaning agent.
For now, the material is being tested further, and researchers have successfully conducted experiments on glass, silicon wafers, aluminum foil and special paper towel surfaces.
In order to make this chemistry more efficient, scientists hope to enhance the efficiency of titanium dioxide in some way.
In addition, scientists must also consider the impact of heavy metals on the astronauts' bodies, such as silver and other heavy metals will enter the condensate in the International Space Station.
Long-term consumption of this body of water can cause damage to internal organs.
Heavy metal damage to the human body

Living with bacteria
Today there are scientific experiments that show that living in space can weaken the immune system of astronauts.
There is no doubt that this will have an impact in the future if the bacteria problem on the space station is not addressed in a timely manner.
And there is no way to remove these bacteria forever, even though they were checked before the flight, but astronauts carry food, household items, including the presence of mites and intestinal flora in their own bodies.

Eventually these bacteria are recycled back to the International Space Station, and it is worth mentioning that there are already more than 50 species of microorganisms in the International Space Station.
And a stable population of microorganisms has been formed.
This means it will be more difficult to eradicate them.
Endeavour's mouse experiments

Returning to the issue of the immune system, scientists found in 2007 in Endeavour experiments on mice that living in space weakened their thymus glands.
The thymus gland serves as an important player in the immune system, producing T cells to help kill potential viral threats.
For humans, long-term space life also affects thymus changes in humans.
Also in a 2019 study, NASA noted that there are actually many dormant viruses lurking in the human body.
The herpes virus, for example, is usually not completely eradicated from the body, but rather suppressed by the immune system.
In addition, the viruses that cause chickenpox and shingles remain in the body's spinal cord cells for life.
Stress affects the pituitary gland of the brain and the entire body

Scientists at the Johnson Space Center said that astronauts living in space for long periods of time face great psychological stress, as well as the relatively greater stress of life, as well as the possibility of reduced immunity.
These factors combined, it is likely to activate the dormant virus in the human body.
Human urine and saliva can be a breeding ground for viral bacteria, so it is vital to address the astronauts' lives.
But these seemingly simple things are often easier said than done.
The International Space Station is the astronauts' second home

Today scientists are still looking for a good solution, or from another point of view, how to make astronauts and these bacteria peacefully coexist, is really a thing worth thinking about.
About the Creator
Evan Tao
Have you gone through a heartbreak that changed you?
Comment below. Let’s create a space for healing, together.
If this story touched you, please share it.
Sometimes, your pain becomes someone else’s lifeline.






Comments
There are no comments for this story
Be the first to respond and start the conversation.